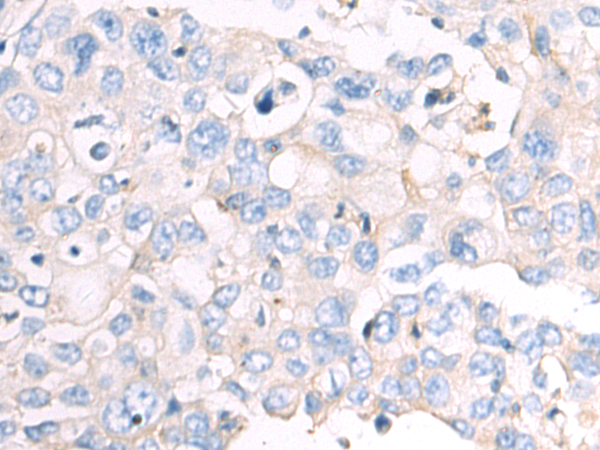

-
分类: 科研抗体货号: P07124别名: CREB2; TXREB; CREB-2; TAXREB67应用: IHC反应种属: Human, Mouse, Rat
-
分类: 科研抗体货号: P07114别名: MSF; MSF1; NAPB; SEPT9; SINT1; PNUTL4; SeptD1; AF17q25应用: IHC反应种属: Human, Mouse, Rat
-
分类: 科研抗体货号: P07134别名: ALK6; ALK-6; CDw293应用: IHC反应种属: Human, Mouse
-
分类: 科研抗体货号: P07122别名: HB16; CREB2; TREB7; CRE-BP1应用: IHC反应种属: Human, Mouse, Rat
-
分类: 科研抗体货号: P07112别名:应用: WB,IHC反应种属: Human, Mouse, Rat
-
分类: 科研抗体货号: P07132别名: ZYME; BMP2B; OFC11; BMP2B1; MCOPS6应用: WB,IHC反应种属: Human, Mouse, Rat
-
分类: 科研抗体货号: P07119别名: Arg3.1应用: WB,IHC反应种属: Human, Mouse, Rat
-
分类: 科研抗体货号: P07111别名: CTS; ATTR; CTS1; PALB; TBPA; HEL111; HsT2651应用: WB,IHC反应种属: Human, Mouse, Rat
-
分类: 科研抗体货号: P07131别名: AMPH2; AMPHL; SH3P9应用: IHC反应种属: Human
-
分类: 科研抗体货号: P07149别名: CAP; CAP1-PEN应用: WB,IHC反应种属: Human, Mouse, Rat

鄂公网安备42018502007531号
鄂公网安备42018502007531号

